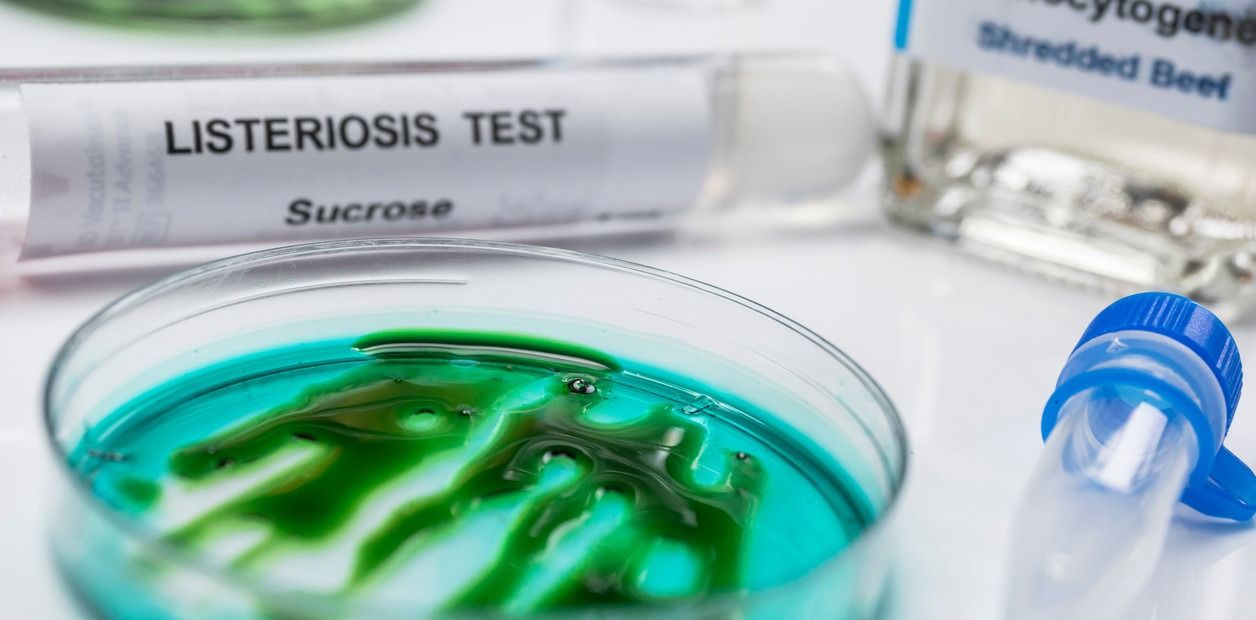
313335_1755006105.jpg

El municipio de Gral Lamadrid impulsa un corte de ruta contra una minera radicada en San Juan, exigiendo puestos de trabajo.
Sociedad
Por primera vez, se vinculan casos humanos de una infección grave con un alimento específico. El brote afecta a tres provincias y pone en foco la seguridad alimentaria.
Martes 12 de Agosto de 2025
10:33 | Martes 12 de Agosto de 2025 | La Rioja, Argentina | Fenix Multiplataforma
El Ministerio de Salud de la Nación confirmó un brote de listeriosis en Argentina, una enfermedad potencialmente mortal causada por la bacteria Listeria monocytogenes. Lo alarmante es que, por primera vez en el país, se logró establecer un vínculo directo entre los casos humanos y un alimento contaminado: un queso criollo de producción industrial de baja escala.
Los primeros casos se detectaron en diciembre de 2024 en la provincia de Buenos Aires, seguidos por otros en Ciudad de Buenos Aires y Tucumán. A raíz de estos episodios, se inició una investigación sanitaria que incluyó entrevistas a los afectados y análisis de alimentos listos para consumir. De las 26 muestras estudiadas, cinco contenían la bacteria, y una de ellas mostró una alta relación genómica con los casos humanos, lo que permitió identificar la planta productora como fuente de la infección.
La listeriosis puede ser leve en personas sanas, pero representa un grave riesgo para embarazadas, bebés, adultos mayores y personas inmunocomprometidas. Los síntomas incluyen fiebre, escalofríos, dolores musculares, vómitos, confusión y, en casos severos, meningitis o septicemia.
El brote evidenció la necesidad de reforzar las buenas prácticas de manufactura, controles sanitarios y educación alimentaria. El Ministerio emitió recomendaciones para prevenir la enfermedad, como mantener la higiene en la cocina, evitar la contaminación cruzada, consumir alimentos bien cocidos y elegir productos lácteos pasteurizados.
DEJANOS TU COMENTARIO
Las Más Vistas

El municipio de Gral Lamadrid impulsa un corte de ruta contra una minera radicada en San Juan, exigiendo puestos de trabajo.

Chilecito: Una trabajadora sexual le robó el reloj a un hombre y le pedía dinero para devolverlo

Le arrebataron la cartera a una mujer mientras esperaba el semáforo en la Capital

Choque entre un auto y una moto en avenida Luis Vernet: un joven fue trasladado al hospital

La Rioja presentó el primer robot humanoide desarrollado en la provincia por jóvenes profesionales
Top Semanal
TAMBIÉN TE PUEDE INTERESAR
LOCALES
NACIONALES
INTERNACIONES
DEPORTES
SOCIEDAD
FARÁNDULA